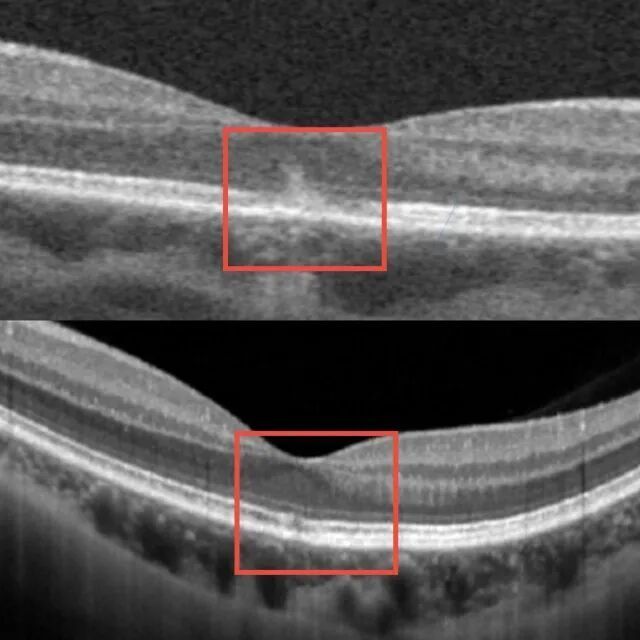
女子美容后视力骤降！请注意，这个操作1秒都不行

“双十一”落幕、“双十二”临近,家用美容仪器市场销售热潮不减。其中,被称为“大排灯”的LED美容仪凭借其多波长光照祛痘、美白、嫩肤等功效,备受消费者追捧。在这股风潮背后,藏着不容忽视的眼健康风险。
近日,浙江省眼科医院(温州医科大学附属眼视光医院)杭州院区神经眼科主任孙传宾主任医师接诊了一名三十来岁的女性患者,她在家中自行使用LED红蓝光美容仪进行面部祛斑治疗时,突然想看一下治疗时间是否结束,提前摘下了防护墨镜,导致强光直射入眼睛,当即出现左眼视力下降和视野中央黑影遮挡。

“生理状态下,墨镜或眼罩遮盖眼睛后,瞳孔会自动散大。一旦有强光射入,瞳孔就像一扇敞开的大门,来不及关上,造成人眼视网膜的黄斑部光损伤。”孙传宾说,经检查,患者的视网膜黄斑区出现暗红色斑点,被确诊为“黄斑热损伤”。
“黄斑是眼底最敏锐的感光组织,一旦受损,可能引发不可逆的视功能损害,甚至失明。”他解释,“幸运的是,患者的强光照射短暂,损伤较轻,经过积极的药物治疗,1周后视力明显改善,1个月后恢复正常。若光照强度更强或曝光时间更久,有可能造成不可逆的损伤,甚至致盲。”
黄斑部光损伤修复前后对比图
近年来,随着家用美容仪普及,医院接诊的类似病例逐渐增多。“很多消费者忽视了说明书中的安全提示,认为‘短短照一下没关系’。强光在一瞬间就会对眼睛造成不可逆的伤害。”
孙传宾建议,以“大排灯”为例,用户在使用时必须全程佩戴专用防护墨镜,并在设备完全停止运行后再摘下,“任何提前摘镜的行为都可能带来风险,1秒钟都不行!消费者在选购时,要注意选择具备光生物安全检测报告的美容仪品牌,并严格遵循使用规范。”
在采访中了解到,很多患者出现视力急剧下降、视野遮挡等症状时,往往不知该挂哪个科,而神经眼科正是为解决此类“疑难杂症”而设立的。
“在门诊中,我经常会接诊其他科室转诊而来的复杂病例。”孙传宾表示,神经眼科是一个眼科与神经内科的交叉学科,专门处理视神经病变、眼球运动障碍等复杂疾病,如视神经炎症、缺血、外伤、中毒、遗传性疾病以及重影(复视)等。
资料/杭州新闻、浙江省眼科医院
文字/叶佳裕


点击右上角![]() 微信好友
微信好友
 朋友圈
朋友圈

点击浏览器下方“ ”分享微信好友Safari浏览器请点击“
”分享微信好友Safari浏览器请点击“ ”按钮
”按钮

点击右上角 QQ
QQ

点击浏览器下方“ ”分享QQ好友Safari浏览器请点击“
”分享QQ好友Safari浏览器请点击“ ”按钮
”按钮
